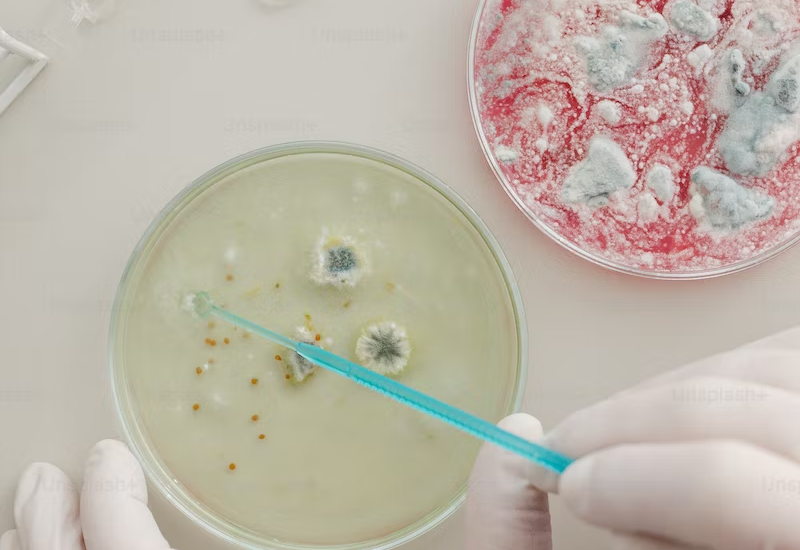
Balancing Chemistry and Compatibility in Modern Relationships

How to balance out both chemistry and compatibility in relationships? Here’s some tips and tricks for you
Read More
Everything about dating, hookups, and sex.
How to balance out both chemistry and compatibility in relationships? Here’s some tips and tricks for you
Read More
Tips on how to build a better and lasting healthy relationship with your SO!
Read More
Take your time and discover authentic relationships
Read More
Want to stop being overly attached and be more independent? yeahh..we’ve all been there.
Read More
The fear of rejection and putting yourself out there
Read More
These are the must do rules to be a gentle man/gentle women
Read More